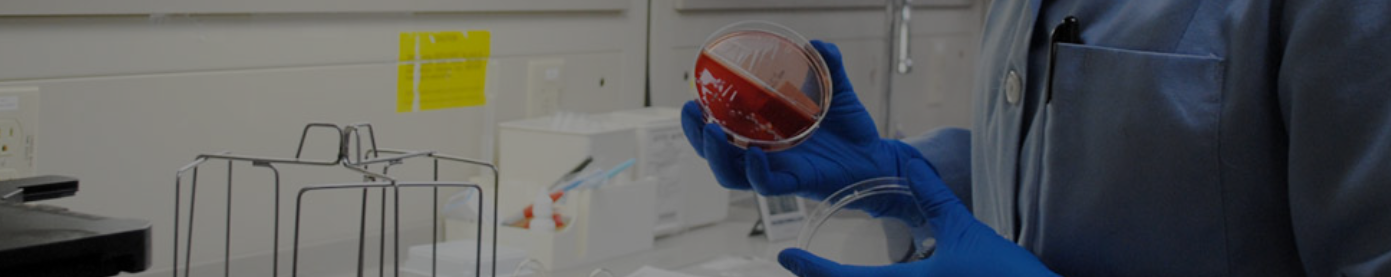
Assistant Professor Jobs
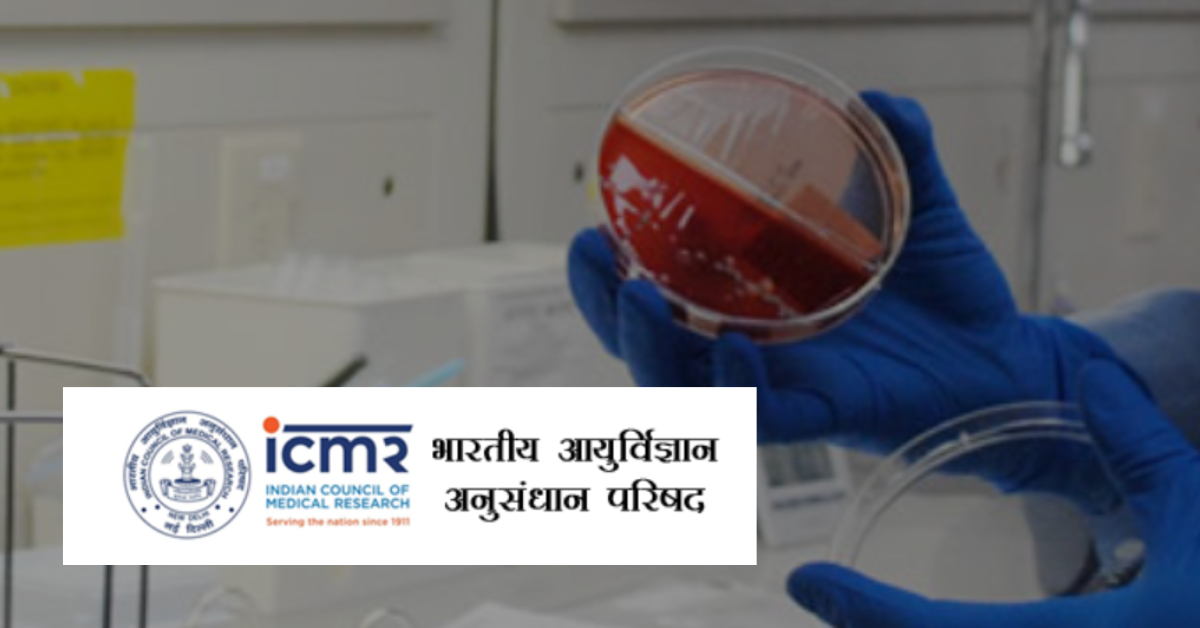
Assistant Professor Jobs

Indian Council of medical research-New Delhi invites Online Applications from eligible candidates for professor and assistant professor post on Regular basis :
Assistant Professor Jobs

Name of the Post
Total Vacancies: 22
- Professor: 3
- Assistant Professor: 19
Category classification
- UR : 10
- SC : 3
- ST : 2
- OBC(NCL) : 7
- EWS : 0
- EXSM : 0
- PwBD : 0
Age Limit
- Age Limit : 40-50 years
Age relaxation
- SC/ST : 5 years
- OBC(NCL) : 3 years
- PWBD : 10 years
- PWD + OBC(NCL) : 13 years
- PWD + SC/ST : 15 years
- Ex-Servicemen(UR) : 03 years
- Ex-Servicemen(SC/ST) : 08 years
- Ex-Servicemen(OBC) : 05 years

Qualification
Assistant Professor Jobs
- Professor: MBBS/Post Graduate Degree
- Assistant Professor: MBBS/Post Graduate Degree
Application Fee
- UR/OBC/EWS candidates : ₹1500
- SC/ST/PwD/Ex serviceman/ women : Exempted
Important Dates
- Opening date of submitting application form : 05.02.2024
- Last date of submission of application form : 16.02.2024
Pay Scale
- Professor: ₹1,23,100-₹2,15,900
- Assistant Professor: ₹67,700-₹2,08,700
Important Links
Recent Jobs
- CPPRI Recruitment 2023
- North Eastern Institute of Ayurveda Recruitment
- TIFR Recruitment Turner machinist Fitter 2023